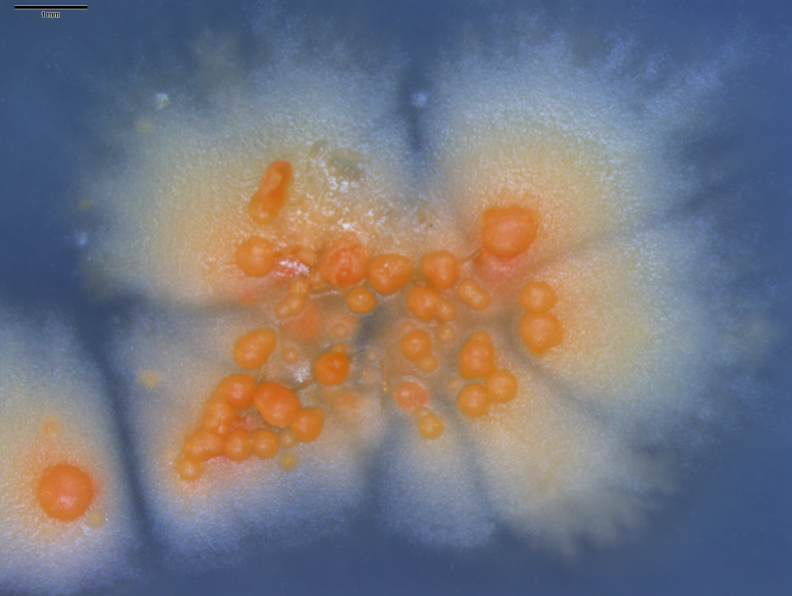

|
Biological Magnetic Resonance Data BankA Repository for Data from NMR Spectroscopy on Proteins, Peptides, Nucleic Acids, and other Biomolecules |
Member of
|
Metabolic profiles of 47 marine bacteriaThe 47 strains of Verrucosispora, Micromonospora, and Nocardia isolated from tropical ascidians, Trididemnum orbiculatum, Didemnum psammathode, and Ecteinascidia turbinate, were used in this proof-of-concept study.Microbial Strain Prioritization Using Metabolomics Tools for the Discovery of Natural Products Yanpeng Hou, Doug R. Braun, Cole R. Michel, Jonathan L. Klassen, Navid Adnani, Thomas P. Wyche, and Tim S. Bugni Analytical Chemistry 2012 84 (10), 4277-4283. Available from http://pubs.acs.org/doi/abs/10.1021/ac202623g |
||||

|
||||
| Strains | Closest match in NCBI (16S) | Ascidians | GeneBank Accession # (16S) |
data files |
|---|---|---|---|---|
| WMMB-202 | Verrucosispora sp. FIM 0657 | Trididemnum orbiculatum | JQ716941 | LC/MS: mzXML 1, mzXML 2 |
| WMMB-203 | Nocardia araoensis W9705 | Trididemnum orbiculatum | JQ716942 | LC/MS: mzXML 1, mzXML 2 |
| WMMB-204 | Verrucosispora sp. 234606 | Trididemnum orbiculatum | JQ716943 | LC/MS: mzXML 1, mzXML 2 |
| WMMB-205 | Verrucosispora sp. FIM 0657 | Trididemnum orbiculatum | JQ716944 | LC/MS: mzXML 1, mzXML 2 |
| WMMB-206 | Verrucosispora sp. FIM 0657 | Trididemnum orbiculatum | JQ716945 | LC/MS: mzXML 1, mzXML 2 |
| WMMB-207 | Nocardia araoensis W9705 | Trididemnum orbiculatum | JQ716946 | LC/MS: mzXML 1, mzXML 2 |
| WMMB-208 | Verrucosispora sp. FIM 0657 | Trididemnum orbiculatum | JQ716947 | LC/MS: mzXML 1, mzXML 2 |
| WMMB-209 | Verrucosispora sp. FIM 0657 | Trididemnum orbiculatum | JQ716948 | LC/MS: mzXML 1, mzXML 2 |
| WMMB-210 | Verrucosispora sp. FIM 0657 | Trididemnum orbiculatum | JQ716949 | LC/MS: mzXML 1, mzXML 2 |
| WMMB-211 | Verrucosispora sp. FIM 0657 | Trididemnum orbiculatum | JQ716950 | LC/MS: mzXML 1, mzXML 2 |
| WMMB-212 | Verrucosispora sp. FIM 0657 | Trididemnum orbiculatum | JQ716951 | LC/MS: mzXML 1, mzXML 2 |
| WMMB-213 | Nocardia sp. W9241 | Trididemnum orbiculatum | JQ716952 | LC/MS: mzXML 1, mzXML 2 |
| WMMB-214 | Verrucosispora sp. FIM 0657 | Trididemnum orbiculatum | JQ716953 | LC/MS: mzXML 1, mzXML 2 |
| WMMB-215 | Nocardia araoensis W9705 | Trididemnum orbiculatum | JN638997 | LC/MS: mzXML 1, mzXML 2 |
| WMMB-216 | Verrucosispora sp. FIM 0657 | Trididemnum orbiculatum | JQ716954 | LC/MS: mzXML 1, mzXML 2 |
| WMMB-217 | Verrucosispora sp. FIM 0657 | Trididemnum orbiculatum | JQ716955 | LC/MS: mzXML 1, mzXML 2 |
| WMMB-218 | Verrucosispora sp. FIM 0657 | Trididemnum orbiculatum | JQ716956 | LC/MS: mzXML 1, mzXML 2 |
| WMMB-219 | Verrucosispora sp. FIM 0657 | Trididemnum orbiculatum | JQ716957 | LC/MS: mzXML 1, mzXML 2 |
| WMMB-220 | Verrucosispora sp. FIM 0657 | Trididemnum orbiculatum | JQ716958 | LC/MS: mzXML 1, mzXML 2 |
| WMMB-221 | Nocardia araoensis W9705 | Didemnum psammathode | JQ716959 | LC/MS: mzXML 1, mzXML 2 |
| WMMB-222 | Nocardia araoensis W9705 | Didemnum psammathode | JQ716960 | LC/MS: mzXML 1, mzXML 2 |
| WMMB-223 | Verrucosispora sp. 234606 | Didemnum psammathode | JQ716961 | LC/MS: mzXML 1, mzXML 2 |
| WMMB-224 | Verrucosispora sp. 234606 | Didemnum psammathode | JQ716962 | LC/MS: mzXML 1, mzXML 2 |
| WMMB-225 | Micromonospora sp. SR15 | Didemnum psammathode | JQ716963 | LC/MS: mzXML 1, mzXML 2 |
| WMMB-226 | Verrucosispora sp. 234606 | Didemnum psammathode | JQ716964 | LC/MS: mzXML 1, mzXML 2 |
| WMMB-227 | Verrucosispora sp. 234606 | Didemnum psammathode | JQ716965 | LC/MS: mzXML 1, mzXML 2 |
| WMMB-228 | Nocardia araoensis W9705 | Didemnum psammathode | JQ716966 | LC/MS: mzXML 1, mzXML 2 |
| WMMB-229 | Nocardia araoensis W9705 | Trididemnum orbiculatum | JQ716967 | LC/MS: mzXML 1, mzXML 2 |
| WMMB-230 | Micromonospora sp. CNS-633_SD | Ecteinascidia turbinata | JQ716968 | LC/MS: mzXML 1, mzXML 2 |
| WMMB-231 | Verrucosispora sp. 234606 | Didemnum psammathode | JQ716969 | LC/MS: mzXML 1, mzXML 2 |
| WMMB-232 | Nocardia araoensis W9705 | Didemnum psammathode | JQ716970 | LC/MS: mzXML 1, mzXML 2 |
| WMMB-233 | Nocardia araoensis W9705 | Didemnum psammathode | JQ716971 | LC/MS: mzXML 1, mzXML 2 |
| WMMB-234 | Verrucosispora sp. 234606 | Ecteinascidia turbinata | JQ716972 | LC/MS: mzXML 1, mzXML 2 |
| WMMB-235 | Micromonospora sp. 106 | Ecteinascidia turbinata | JQ716973 | LC/MS: mzXML 1, mzXML 2 |
| WMMB-236 | Verrucosispora sp. 234606 | Ecteinascidia turbinata | JQ716974 | LC/MS: mzXML 1, mzXML 2 |
| WMMB-237 | Verrucosispora sp. 234606 | Ecteinascidia turbinata | JQ716975 | LC/MS: mzXML 1, mzXML 2 |
| WMMB-238 | Verrucosispora sp. 234606 | Ecteinascidia turbinata | JQ716976 | LC/MS: mzXML 1, mzXML 2 |
| WMMB-239 | Nocardia sp. CNS044 PL04 | Didemnum psammathode | JQ716977 | LC/MS: mzXML 1, mzXML 2 |
| WMMB-240 | Verrucosispora sp. 234606 | Ecteinascidia turbinata | JQ716978 | LC/MS: mzXML 1, mzXML 2 |
| WMMB-241 | Verrucosispora sp. 234606 | Ecteinascidia turbinata | JQ716979 | LC/MS: mzXML 1, mzXML 2 |
| WMMB-242 | Verrucosispora sp. 234606 | Ecteinascidia turbinata | JQ716980 | LC/MS: mzXML 1, mzXML 2 |
| WMMB-243 | Verrucosispora sp. 234606 | Ecteinascidia turbinata | JQ716981 | LC/MS: mzXML 1, mzXML 2 |
| WMMB-244 | Verrucosispora sp. 234606 | Ecteinascidia turbinata | JQ716982 | LC/MS: mzXML 1, mzXML 2 |
| WMMB-245 | Verrucosispora sp. 234606 | Ecteinascidia turbinata | JQ716983 | LC/MS: mzXML 1, mzXML 2 |
| WMMB-247 | Micromonospora sp. JSM5-1 | Ecteinascidia turbinata | JQ716984 | LC/MS: mzXML 1, mzXML 2 |
| WMMB-248 | Micromonospora sp. 399K7-1 | Ecteinascidia turbinata | JQ716985 | LC/MS: mzXML 1, mzXML 2 |
| WMMB-249 | Verrucosispora sp. 234606 | Ecteinascidia turbinata | JQ716986 | LC/MS: mzXML 1, mzXML 2 |